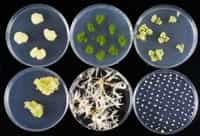

Nel mondo frenetico di oggi, molti abitanti delle zone urbane spendono più del 80% della propria giornata in casa. E non potendo più vivere il rapporto con la natura all’aria aperta, si portano piante e fiori negli ambienti chiusi. Oltre alla loro bellezza estetica, le piante d’appartamento dimostrano di offrire vantaggi psicologici, come ad esempio riduzione della tensione, miglioramento dei meccanismi di adattamento, e una maggiore concentrazione ed attenzione. Da tempo le ricerche hanno accertato che la presenza di piante nelle case e nei luoghi di lavoro possano ridurre l’irritazione degli occhi e lo stress, motivare i dipendenti, migliorare la concentrazione, e anche ridurre le impurità dell’aria. Le piante d’arredamento hanno un effetto positivo sul mal di testa e sull’affaticamento, alcuni lavoratori hanno anche riferito di avere la pelle meno secca quando vi erano piante in ufficio. Ovviamente le piante determinano così un netto aumento della produttività dei lavoratori. Per valutare l’effetto delle piante non solo sul lavoro ma anche sullo studio e sul grado di apprendimento, Jennifer S. Doxey e Tina Marie Waliczek del Dipartimento di Agricoltura, Texas State University, e Jayne M. Zajicek del Dipartimento di Scienze Horticultural, Texas A & M University, hanno pubblicato uno studio degli effetti delle piante in aule universitarie in un recente numero di HortScience. Il loro principale obiettivo era valutare l’impatto delle piante nelle classi sui risultati degli studenti a fine corso e sul grado di soddisfazione del corso. Hanno partecipato allo studio tre gruppi di due classi ciascuna, per un totale di 385 studenti. Ogni coppia di classe ha frequentato uno stesso corso seguito da un unico docente per l’intera durata di un semestre. Il gruppo sperimentale ha partecipato alle lezioni in un aula allestita con piante tropicali; il gruppo di controllo ha partecipato alle lezioni in stanze senza piante. Alla fine del semestre, i ricercatori non hanno trovato differenze significative per rendimento scolastico nei diversi gruppi. Ma di particolare interesse è risultato il diverso grado di soddisfazione riguardo l’entusiasmo e l’organizzazione del docente. Gli studenti che hanno seguito in aule ricche di piante hanno gradito di più questi elementi del corso. Inoltre nel confronto sembra che fossero più soddisfatti gli studenti che erano stati in aule con finestre. Dunque conclude Waliczek: “I nostri risultati hanno dimostrato che le piante d’arredamento ed alcuni elementi architettonici, come le finestre, migliorano l’ambiente che ci circonda. Il nostro studio sostiene altre ricerche che dimostrano che le piante hanno un valore al di là dell’estetica in ambienti interni, compresa la promozione di sentimenti positivi in studenti universitari”.
Potrebbe interessarti
I bambini prematuri possono avere difficoltà a scuola
Una ricerca del gruppo di studio EPICure, finanziato dal Medical Research Council, condotta su 216 bambini di 11 anni nati prima della 26° settimana di gravidanza ha evidenziato che i bambini prematuri sono maggiormente predisposti a manifestare problemi di rendimento scolastico. Lo studio inglese, il secondo di questo genere, ha dato i seguenti risultati: I… Continua a leggere I bambini prematuri possono avere difficoltà a scuola
Meditare per salvare il cuore
Prevenire infarto e ictus attraverso la meditazione trascendentale: è questa la nuova terapia proposta dall’American Heart Association. Durante il congresso dell’associazione sono stati riportati i risultati di uno studio che ha coinvolto duecento soggetti a rischio di malattie coronariche; in nove anni i pazienti, sotto la guida di esperti di meditazione, hanno imparato a respirare… Continua a leggere Meditare per salvare il cuore
Più basso il livello di istruzione, più alta la sensibilità all’influenza
Le persone che non hanno un diploma di scuola superiore, rispetto a quelle con un livello di istruzione più elevato, potrebbero essere colpite più facilmente dal virus H1N1 e per loro il vaccino potrebbe essere meno efficace. Lo dimostra un recente studio dal titolo “differenze socioeconomiche nella risposta immunitaria “. Il lavoro, effettuato da ricercatori… Continua a leggere Più basso il livello di istruzione, più alta la sensibilità all’influenza
I cannabinoidi possibili farmaci per la cura dello stress
L’uso di cannabinoidi (marijuana) potrebbe essere utile per il trattamento dei pazienti con disturbo da stress post-traumatico. Lo domostra un nuovo studio effettuato presso il Learning and Memory Lab, Università di Haifa Dipartimento di Psicologia. Lo studio, svolto da una ricerca degli studenti Eti-Ganon Elazar sotto la supervisione di Irit Akirav, è stata pubblicata nel… Continua a leggere I cannabinoidi possibili farmaci per la cura dello stress
Lacrime e buona salute
Anche gli uomini piangono, ma il record della lacrima va alle donne, che piangono circa un giorno su sei, per un totale di 64 volte l’anno. Il quadruplo, cioe’, rispetto al massimo di 17 volte dell’uomo (in media una volta ogni 22 giorni). E’ quanto emerge da uno studio dell’Associazione tedesca degli oftalmologi. Per le… Continua a leggere Lacrime e buona salute